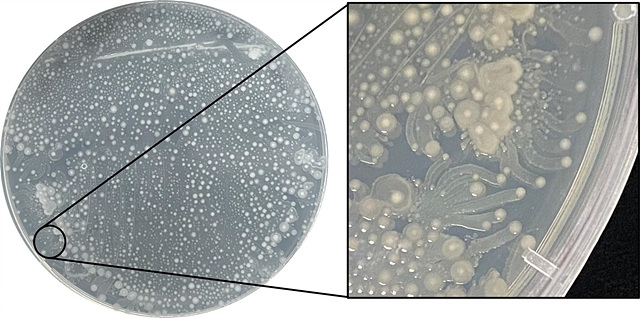

남극 빙하 속에서 오랜시간 잠들어 있던 미생물 가운데 일부가 인체감염 가능성이 있는 것으로 확인됐다.
극지연구소 김옥선 박사 연구팀은 남극장보고과학기지 인근 스틱스(Styx) 빙하에서 서기 520~1980년에 형성된 층에서 총 27종 656개 균주를 채취해 배양하고, 이 가운데 9종 55개 균주에 대해 '잠재적 병원성 세균 후보'로 분류했다고 27일 밝혔다. 인체감염 가능성이 있기 때문읻.
빙하는 과거 기후를 기록한 '얼음 연대기'이자, 눈이나 에어로졸과 함께 유입된 미생물을 장기간 가둬두는 거대한 '자연 저장고'다. 북극 영구동토층에서는 과거 병원균이 되살아난 사례가 보고된 바 있지만, 남극 빙하 미생물과 그 위험성에 대한 연구가 보고된 것은 많지 않았다.
그런 점에서 이번 연구는 시사하는 바가 크다. 연구팀 김민경 박사는 "미생물 중 일부는 결핵균처럼 인체 세포에 달라붙고 면역 반응을 회피하는 유전자를 갖고 있었으며, 또다른 일부에서는 물고기나 생쥐 등 실험동물에 치명적인 영향을 준 세포 용해 유전자와 유사한 서열이 발견됐다"고 밝혔다.
아울러 몇몇 미생물에서는 사람의 정상체온인 37℃ 조건에서 적혈구를 파괴하는 경미한 '용혈 반응'이 관찰됐다. 이는 면역력이 저하된 사람에게 잠재적 위험이 될 수 있음을 시사한다.
스틱스 빙하코어는 장보고기지가 설립되던 2014년 극지연구소가 남극에서 처음으로 자체 확보한 총길이 210m의 시료로, 약 2000년 전의 환경을 연구할 수 있다. 빙하코어는 빙하를 원통형으로 시추해 채취한 것으로, 각 층에 형성 당시의 기후와 생물 정보가 보존돼 있다.
신형철 극지연구소 소장은 "기후변화로 빙하가 녹으면서 오랫동안 갇혀 있던 미생물이 노출돼 인간과 접촉 가능성이 커지고 있다"며 "이번 연구는 남극 빙하 미생물의 다양성과 잠재적 위험성을 이해하는 중요한 기초자료가 될 것"이라고 말했다.
이번 연구결과는 국제학술지 '환경공학(Environmental Research) 7월호에 게재됐다.
Copyright @ NEWSTREE All rights reserved.

- 박진영 기자 jyp7178 다른기사보기